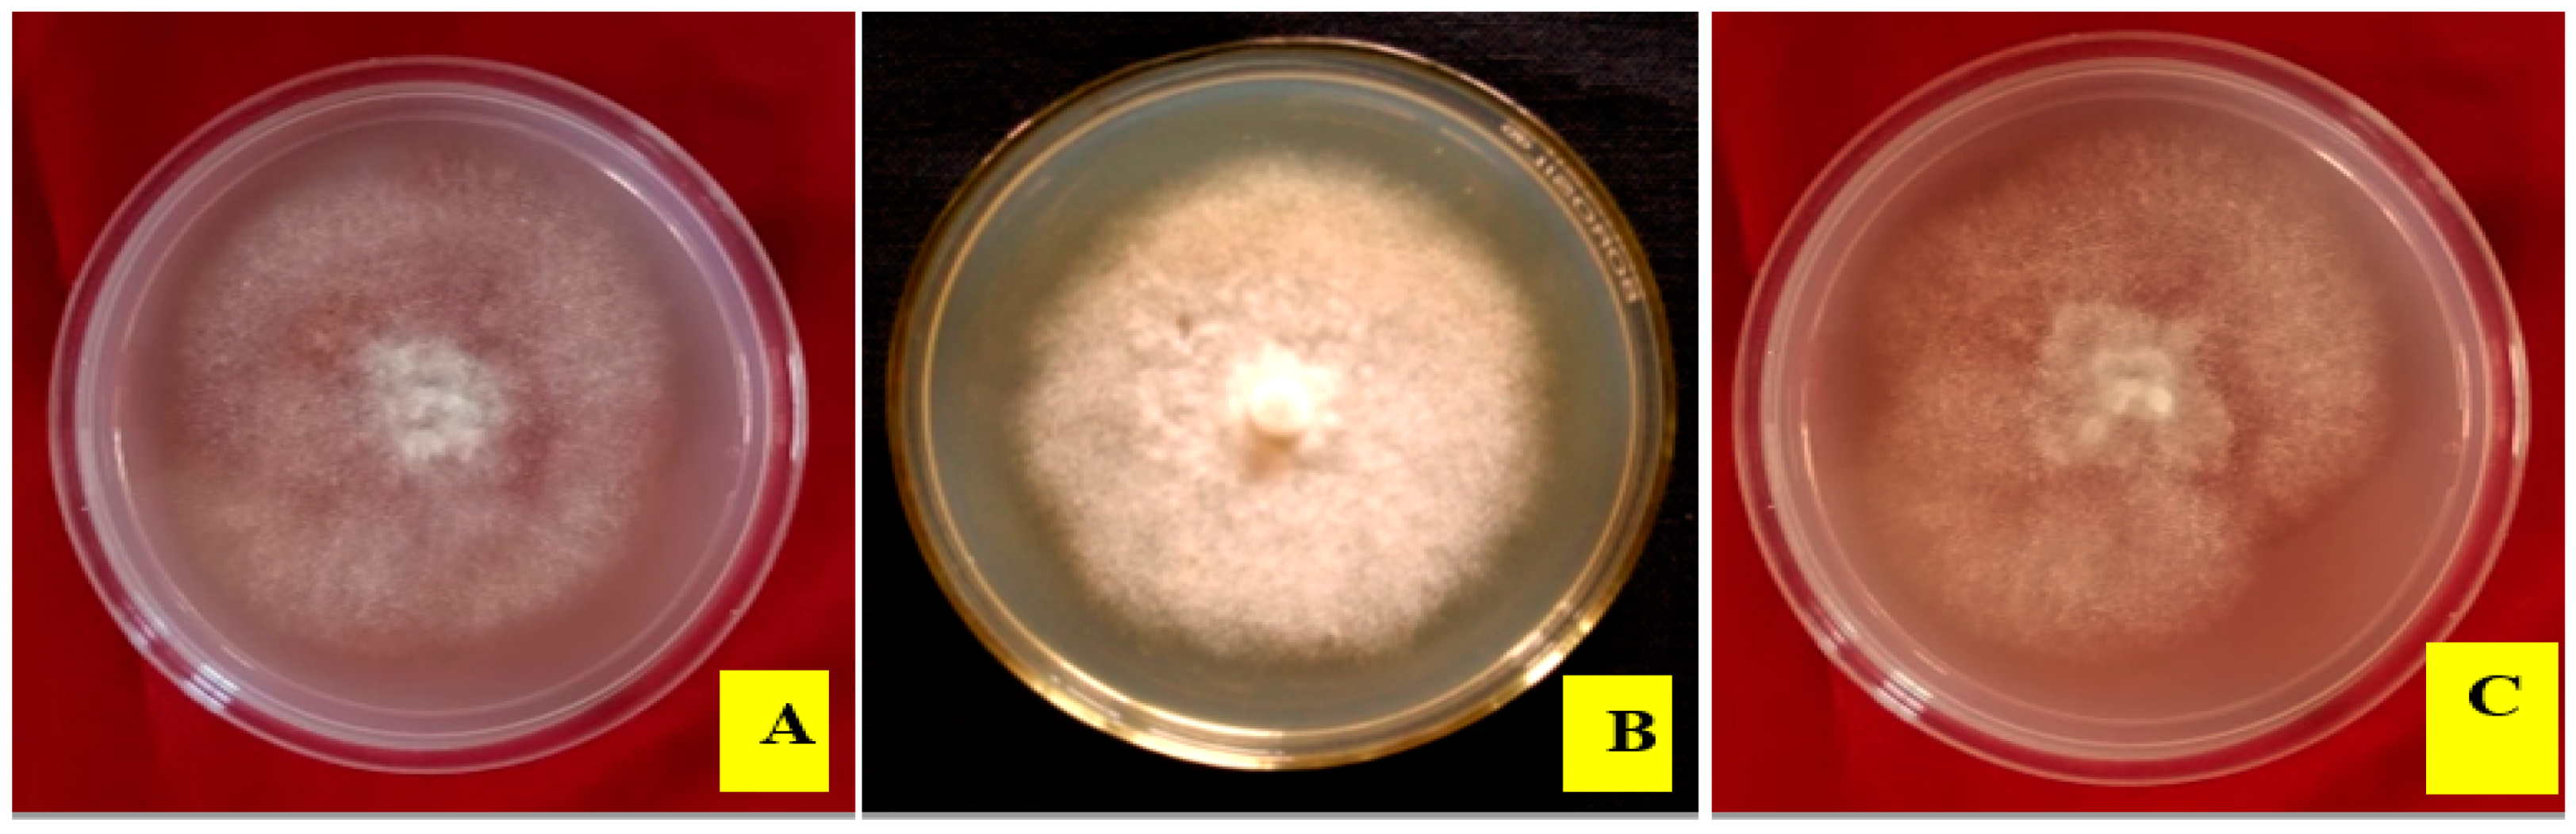
Agronomy 14 00661 g003

Phytophthora Infection Reorients the Composition of Rhizospheric Microbial Assembly in Khasi Mandarin (Citrus reticulata Blanco)
Abstract
1. Introduction
2. Materials and Methods
2.1. Rhizospheric Soil Sampling and Isolation of Pathogen
2.2. Molecular Characterization
2.3. Pathogenicity Test
2.4. Isolation and Identification of Culturable Fungi from Healthy and Diseased Plant Rhizosphere
2.5. Bioinformatics Analysis
2.5.1. Metagenomic Analysis
2.5.2. Quantitative Analysis
Shannon–Weiner Diversity Index
Shannon–Weiner Evenness Index
3. Results
3.1. Identification and Characterization of Pathogen
3.2. Morpho-Cultural Characteristics and Molecular Identification of Pathogen
3.3. In Vitro Studies on Pathogenicity on Different Plant Parts
3.4. Identification of Microbes from Diseased and Healthy Rhizospheres
3.5. Morphological Characterization and Relative Abundance of Isolated Fungal Species
3.6. Diversity of Rhizospheric Bacterial and Fungal Communities
3.7. Metagenomics Analysis
3.8. Diversity and Abundance of Bacterial Phyla in Diseased vs. Healthy Rhizospheres
3.9. Diversity and Abundance of Fungi in Soil Samples
4. Discussion
5. Conclusions
Author Contributions
Funding
Data Availability Statement
Acknowledgments
Conflicts of Interest
References
- Lynch, J.M.; Whipps, J.M. Substrate flow in the rhizosphere. Plant Soil 1990, 129, 1–10. [Google Scholar] [CrossRef]
- Hiltner, L. Über neuere Erfahrungen und Probleme auf dem Gebiet der Bodenbakteriologie und unter besonderer Berücksichtigung der Gründüngung und Brache. Arb. Dtsch. Landwirtsch. Ges. 1904, 98, 59. [Google Scholar]
- Bulgarelli, D.; Rott, M.; Schlaeppi, K.; Ver Loren van Themaat, E.; Ahmadinejad, N.; Assenza, F.; Rauf, P.; Huettel, B. Revealing structure and assembly cues for Arabidopsis root-inhabiting bacterial microbiota. Nature 2012, 488, 91–95. [Google Scholar] [CrossRef] [PubMed]
- Mendes, R.; Garbeva, P.; Raaijmakers, J.M. The rhizosphere microbiome: Significance of plant beneficial, plant pathogenic, and human pathogenic microorganisms. FEMS Microbiol. Rev. 2013, 337, 634–663. [Google Scholar] [CrossRef]
- Ginnan, N.A.; Dang, T.; Bodaghi, S.; Ruegger, P.M.; McCollum, G.; England, G.; Vidalakis, G.; Borneman, J.; Rolshausen, P.E.; Roper, M.C. Disease-induced microbial shifts in citrus indicate microbiome -derived response to huanglongbing across disease severity spectrum. Phytobiomes J. 2020, 4, 357–387. [Google Scholar] [CrossRef]
- Srivastava, A.K.; Das, A.K.; Jagannadham, P.T.K.; Bora, P.; Ansari, F.A.; Bhate, R. Bioprospecting microbiome for soil and plant health management amidst huanglongbing threat in citrus: A review. Front. Plant Sci. 2022, 13, 858842. [Google Scholar] [CrossRef]
- Yuan, J.; Zhao, J.; Wen, T.; Zhao, M.; Li, R.; Goossens, P.; Huang, Q.; Bai, Y.; Vivanco, J.M.; Kowalchuk, G.A.; et al. Root exudates drive the soil-borne legacy of aboveground pathogen infection. Microbiome 2018, 6, 156. [Google Scholar] [CrossRef]
- Berg, G.; Köberl, M.; Rybakova, D.; Müller, H.; Grosch, R.; Smalla, K. Plant microbial diversity is suggested as the key to future biocontrol and health trends. FEMS Microbiol. Ecol. 2017, 93, fix50. [Google Scholar] [CrossRef]
- Ploetz, R.C. (Ed.) Diseases of Tropical Fruit Crops; CABI Publishing: Wallingford, UK, 2003. [Google Scholar]
- Van Tran, Q.; Ha, C.V.; Vvedensky, V.V.; Han, V.C. Current status and characterization of Phytophthora-associated with gummosis of citrus in northern Vietnam. J. Phytopathol. 2023, 171, 478–488. [Google Scholar] [CrossRef]
- Lai, Z.; Vinod, K.M.; Zheng, Z.; Fan, B.; Chen, Z. Roles of Arabidopsis WRKY3 and WRKY4 transcription factors in plant responses to pathogens. BMC Plant Biol. 2008, 8, 68. [Google Scholar] [CrossRef] [PubMed]
- Yang, C.; Ancona, V. Metagenomic analysis reveals reduced beneficial microorganism associations in roots of foot-rot-affected citrus trees. Phytobiomes J. 2021, 5, 305–315. [Google Scholar] [CrossRef]
- Srivastava, A.K.; Singh, S. Citrus nutrition research in India; problems and prospects. Indian J. Agric. Sci. 2008, 78, 3–16. [Google Scholar]
- Singh, A.K.; Meetei, N.T.; Singh, B.K.; Mandal, N. Khasi mandarin: Its importance, problems and prospects of cultivation in North-eastern Himalayan region. Int. J. Agric. Environ. Biotechnol. 2016, 9, 573–592. [Google Scholar] [CrossRef]
- Kakoti, R.K.; Nath, P.D.; Borah, M.; Bora, S. Incidence of citrus greening disease in some major khasi mandarin growing areas in upper Brahmaputra valley zone of Assam. J. Plant Dis. Sci. 2022, 17, 93–100. [Google Scholar] [CrossRef]
- Balasubramanian, P.; Kumar, P.G. Insect pests of Khasi Mandarin in east and west Khasi hills district of Meghalaya. Indian J. Entomol. 2022, 85, 238–240. [Google Scholar] [CrossRef]
- Deka, S.; Sehgal, M.; Kakoti, R.K.; Barbora, A.C. Module analysis for insect pest management of khasi mandarin (Citrus reticulata Blanco) under climatic conditions of north-eastern India. J. Entomol. Zool. Stud. 2018, 6, 857–861. [Google Scholar]
- Prabha, T.R.; Revathi, K.; Vinod, M.S.; Shanthakumar, S.P.; Bernard, P. Shanthakumar, and Paul Bernard. A simple method for total genomic DNA extraction from water moulds. Curr. Sci. 2013, 104, 345–347. [Google Scholar]
- Das, A.K.; Nerkar, S.; Thakre, N.; Kumar, A. First report of an atypical strain of Phytophthora inundata causing Kinnow mandarin decline in India. Can. J. Plant Pathol. 2017, 39, 365–372. [Google Scholar] [CrossRef]
- Rocha, J.D.R.D.S.; Oliveira, N.T.D.; Menezes, M. Comparison of inoculation methods efficiency for evaluation of Colletotrichum gloeosporioides isolates pathogenicity on passion fruits (Passiflora Edulis). Braz. Arch. Biol. Technol. 1998, 41, 140–148. [Google Scholar] [CrossRef]
- Chowdhry, P.N.; Varshney, A. Identification of different Colletotrichum goleosporides species. In Manual on Identification of Plant Pathogenic and Biocontrol Fungi of Agricultural Importance; IARI: New Delhi, India, 2000; pp. 73–78. [Google Scholar]
- Subramanian, C.V. Hyphomycetes; an Account of Indian Species Except Cercosporae; Indian Council of Agricultural Research: New Delhi, India, 1971. [Google Scholar]
- Barnett, H.L.; Hunter, B.B. Illustrated genera of imperfect fungi. In Illustrated Genera of Imperfect Fungi, 3rd ed.; Burgess Publishing Company: Minneapolis, MN, USA, 1972. [Google Scholar]
- Ellis, M.B. Dematiaceous Hyphomycetes; Commonwealth Mycological Institute: Kew, UK, 1971. [Google Scholar]
- Domsch, K.H.; Gams, W.; Anderson, T.H. Compendium of Soil Fungi. Volume 1; Academic Press (London) Ltd.: London, UK, 1980. [Google Scholar]
- Li, D.; Liu, C.M.; Luo, R.; Sadakane, K.; Lam, T.W. MEGAHIT: An ultra-fast single-node solution for large and complex metagenomics assembly via succinct de Bruijn graph. Bioinformatics 2015, 31, 1674–1676. [Google Scholar] [CrossRef]
- Menzel, P.; Ng, K.L.; Krogh, A. Fast and sensitive taxonomic classification for metagenomics with Kaiju. Nat. Commun. 2016, 7, 11257. [Google Scholar] [CrossRef] [PubMed]
- Shannon, C.E. A mathematical theory of communication. Bell Syst. Tech. J. 1948, 27, 379–423. [Google Scholar] [CrossRef]
- Mekonen, M.; Ayalew, A.; Weldetsadik, K.; Seid, A. Assessing and measuring of Citrus gummosis (Phytophthora spp.) in major citrus growing areas of Ethiopia. J. Hortic. 2015, 2, 1–4. [Google Scholar] [CrossRef]
- Das, A.K.; Kumar, A.; Ingle, A.; Nerkar, S. Molecular identification of Phytophthora spp. causing citrus decline in Vidarbha region of Maharashtra. Indian Phytopathol. 2011, 64, 342. [Google Scholar]
- El-Guilli, M.; Benyahia, H.; Jrifi, A.; Besri, M. Effect of irrigation water salinity on trunk gummosis symptom severity for citrus affected with Phytophthora citrophthora. Fruits 2000, 55, 181–186. [Google Scholar]
- Hall, G. An integrated approach to the analysis of variation in Phytophthora nicotianae and a redescription of the species. Mycol. Res. 1993, 97, 559–574. [Google Scholar] [CrossRef]
- Waterhouse, G.M. Phytophthora palmivora and some related species. In Phytophthora Disease of Cocoa; Gregory, P.H., Ed.; Longman: London, UK, 1974. [Google Scholar]
- Thomson, S.V.; Hine, R.B. Atypical sporangium-like structures of Phytophthora parasitica. Mycologia 1972, 64, 457–460. [Google Scholar] [CrossRef]
- Ho, H.H.; Ann, P.J.; Chang, H.S. The Genus Phytophthora in Taiwan; Institute of Botany, Academia Sinica: Nangang, Taipei, 1995. [Google Scholar]
- Bora, P.; Bora, L.C. Disease management in horticultural crops through microbial interventions: An overview. Indian J. Agric. Sci. 2020, 90, 1384–1396. [Google Scholar]
- Saikia, S.; Bora, P.; Bora, L.C. Bioagent mediated management of citrus canker. Indian J. Agric. Sci. 2021, 91, 198–201. [Google Scholar] [CrossRef]
- Zhang, Y.; Trivedi, P.; Xu, J.; Roper, M.C.; Wang, N. The citrusmicrobiome: From structure and function to microbiome engineering and beyond. Phytobiomes J. 2021, 5, 249–261. [Google Scholar] [CrossRef]
- Solís-García, I.A.; Ceballos-Luna, O.; Cortazar-Murillo, E.M.; Desgarennes, D.; Garay-Serrano, E.; Patiño-Conde, V.; Méndez-Bravo, A.; Reverchon, F. Phytophthora root rot modifies the composition of the avocado rhizosphere microbiome and increases the abundance of opportunistic fungal pathogens. Front. Microbiol. 2021, 11, 3484. [Google Scholar] [CrossRef] [PubMed]
- Win, T.T.; Bo, B.; Malec, P.; Khan, S.; Fu, P. Newly isolated strain of Trichoderma asperellum from disease suppressive soil is a potential bio-control agent to suppress Fusarium soil borne fungal phytopathogens. J. Plant Pathol. 2021, 103, 549–561. [Google Scholar] [CrossRef]
- Bora, P.; Saikia, K.; Hazarkia, H.; Ragesh, G. Exploring potential of bacterial endophytes in disease management. Curr. Hortic. 2019, 7, 32–37. [Google Scholar] [CrossRef]

| Morpho-Cultural Characteristics | ||||||||||
|---|---|---|---|---|---|---|---|---|---|---|
| Pigmentation | Shape | Margin | Topography | Colony Colour | Papillate/Non-Papillate | Shape (Sporangia) | Mean L: B Ratio | Size (Sporangia B × L) (µm) | Location | Isolate |
| None | Irregular | Smooth | Flat to Fluffy | White | Papillate | Ovoid | 1.67 | 26.6–27.2 × 44.8–45.3 | Khaman Pathar | P1 |
| None | Irregular | Smooth | Flat | White | Papillate | Obpyriform | 1.52 | 29.7–30.5 × 42.8–49.1 | Motapung | P2 |
| None | Irregular | Smooth | Fluffy | White | Papillate | Ovoid | 1.99 | 24.3–25.7 × 49.5–50.3 | Kamalabari | P3 |
| Relative Abundance (%) | Identified Species | |||||
|---|---|---|---|---|---|---|
| Diseased Rhizosphere | Healthy Rhizosphere | |||||
| Kamalabari | Motapung | Khaman Pathar | Kamalabari | Motapung | Khaman Pathar | |
| 52.98 | 42.15 | 42.41 | 12.86 | 28.03 | 36.67 | Fusarium spp. |
| 19.25 | 12.38 | 14.41 | 23.34 | 72.61 | 21.03 | Penicillium spp. |
| 17.86 | 18.76 | 12.24 | 19.35 | 4.81 | 7.98 | Aspergillus spp. |
| 3.37 | 3.97 | 8.35 | 4.23 | 32.06 | 8.56 | Acremonium spp. |
| 4.76 | 6.32 | 13.67 | 6.23 | 25.61 | 6.64 | Mucor spp. |
| 1.39 | 9.71 | 6.56 | 4.83 | 10.81 | 3.04 | Geotrichum spp. |
| 0.40 | 6.71 | 2.37 | 9.22 | 20.42 | 2.59 | Culvularia spp. |
| 0.01 | 0.00 | 0.00 | 19.93 | 25.65 | 13.50 | Trichoderma spp. |
| Fungal Population (×103 CFU per Gram Moist Soil) | Bacterial Population (×103 CFU per Gram Moist Soil) | Location | ||
|---|---|---|---|---|
| Healthy | Infected | Healthy | Diseased | |
| 4.6 × 10−4 ± 0.367 | 4.1 × 10−4 ± 0.666 | 6.1 × 10−6 ± 0.100 | 2.3 × 10−6 ± 0.120 * | Motapung |
| 4.8 × 10−4 ± 0.167 | 4.0 × 10−4 ± 0.533 | 5.2 × 10−6 ± 0.416 | 4.2 × 10−6 ± 0.967 | Khaman Pathar |
| 3.6 × 10−4 ± 0.493 | 2.9 × 10−4 ± 0.033 | 4.8 × 10−6 ± 0.240 | 4.6 × 10−6 ± 1.299 | Kamalabari |
| Relative Abundance (%) | Identified Species | |||||
|---|---|---|---|---|---|---|
| Diseased Rhizosphere | Healthy Rhizosphere | |||||
| Kamalabari | Motapung | Khaman Pathar | Kamalabari | Motapung | Khaman Pathar | |
| 52.98 | 42.15 | 42.41 | 12.86 | 28.03 | 36.67 | Fusarium spp. |
| 19.25 | 12.38 | 14.41 | 23.34 | 72.61 | 21.03 | Penicillium spp. |
| 17.86 | 18.76 | 12.24 | 19.35 | 4.81 | 7.98 | Aspergillus spp. |
| 3.37 | 3.97 | 8.35 | 4.23 | 32.06 | 8.56 | Acremonium spp. |
| 4.76 | 6.32 | 13.67 | 6.23 | 25.61 | 6.64 | Mucor spp. |
| 1.39 | 9.71 | 6.56 | 4.83 | 10.81 | 3.04 | Geotrichum spp. |
| 0.40 | 6.71 | 2.37 | 9.22 | 20.42 | 2.59 | Culvularia spp. |
| 0.01 | 0.00 | 0.00 | 19.93 | 25.65 | 13.50 | Trichoderma spp. |
| Metrics | DAM_H | DAM_D |
|---|---|---|
| num_seqs | 14,645 | 2137 |
| sum_len | 25,212,086 | 2,700,710 |
| min_len | 1000 | 1000 |
| avg_len | 1721.5 | 1263.8 |
| max_len | 60,163 | 24,564 |
| med_len | 1258 | 1151 |
| N50 | 1573 | 1193 |
Disclaimer/Publisher’s Note: The statements, opinions and data contained in all publications are solely those of the individual author(s) and contributor(s) and not of MDPI and/or the editor(s). MDPI and/or the editor(s) disclaim responsibility for any injury to people or property resulting from any ideas, methods, instructions or products referred to in the content. |
© 2024 by the authors. Licensee MDPI, Basel, Switzerland. This article is an open access article distributed under the terms and conditions of the Creative Commons Attribution (CC BY) license (https://creativecommons.org/licenses/by/4.0/).
Share and Cite
Handique, M.; Bora, P.; Ziogas, V.; Srivastava, A.K.; Jagannadham, P.T.K.; Das, A.K. Phytophthora Infection Reorients the Composition of Rhizospheric Microbial Assembly in Khasi Mandarin (Citrus reticulata Blanco). Agronomy 2024, 14, 661. https://doi.org/10.3390/agronomy14040661
Handique M, Bora P, Ziogas V, Srivastava AK, Jagannadham PTK, Das AK. Phytophthora Infection Reorients the Composition of Rhizospheric Microbial Assembly in Khasi Mandarin (Citrus reticulata Blanco). Agronomy. 2024; 14(4):661. https://doi.org/10.3390/agronomy14040661
Chicago/Turabian StyleHandique, Mridupol, Popy Bora, Vasileios Ziogas, Anoop Kumar Srivastava, Prasanth Tej Kumar Jagannadham, and Asish Kumar Das. 2024. "Phytophthora Infection Reorients the Composition of Rhizospheric Microbial Assembly in Khasi Mandarin (Citrus reticulata Blanco)" Agronomy 14, no. 4: 661. https://doi.org/10.3390/agronomy14040661
APA StyleHandique, M., Bora, P., Ziogas, V., Srivastava, A. K., Jagannadham, P. T. K., & Das, A. K. (2024). Phytophthora Infection Reorients the Composition of Rhizospheric Microbial Assembly in Khasi Mandarin (Citrus reticulata Blanco). Agronomy, 14(4), 661. https://doi.org/10.3390/agronomy14040661

